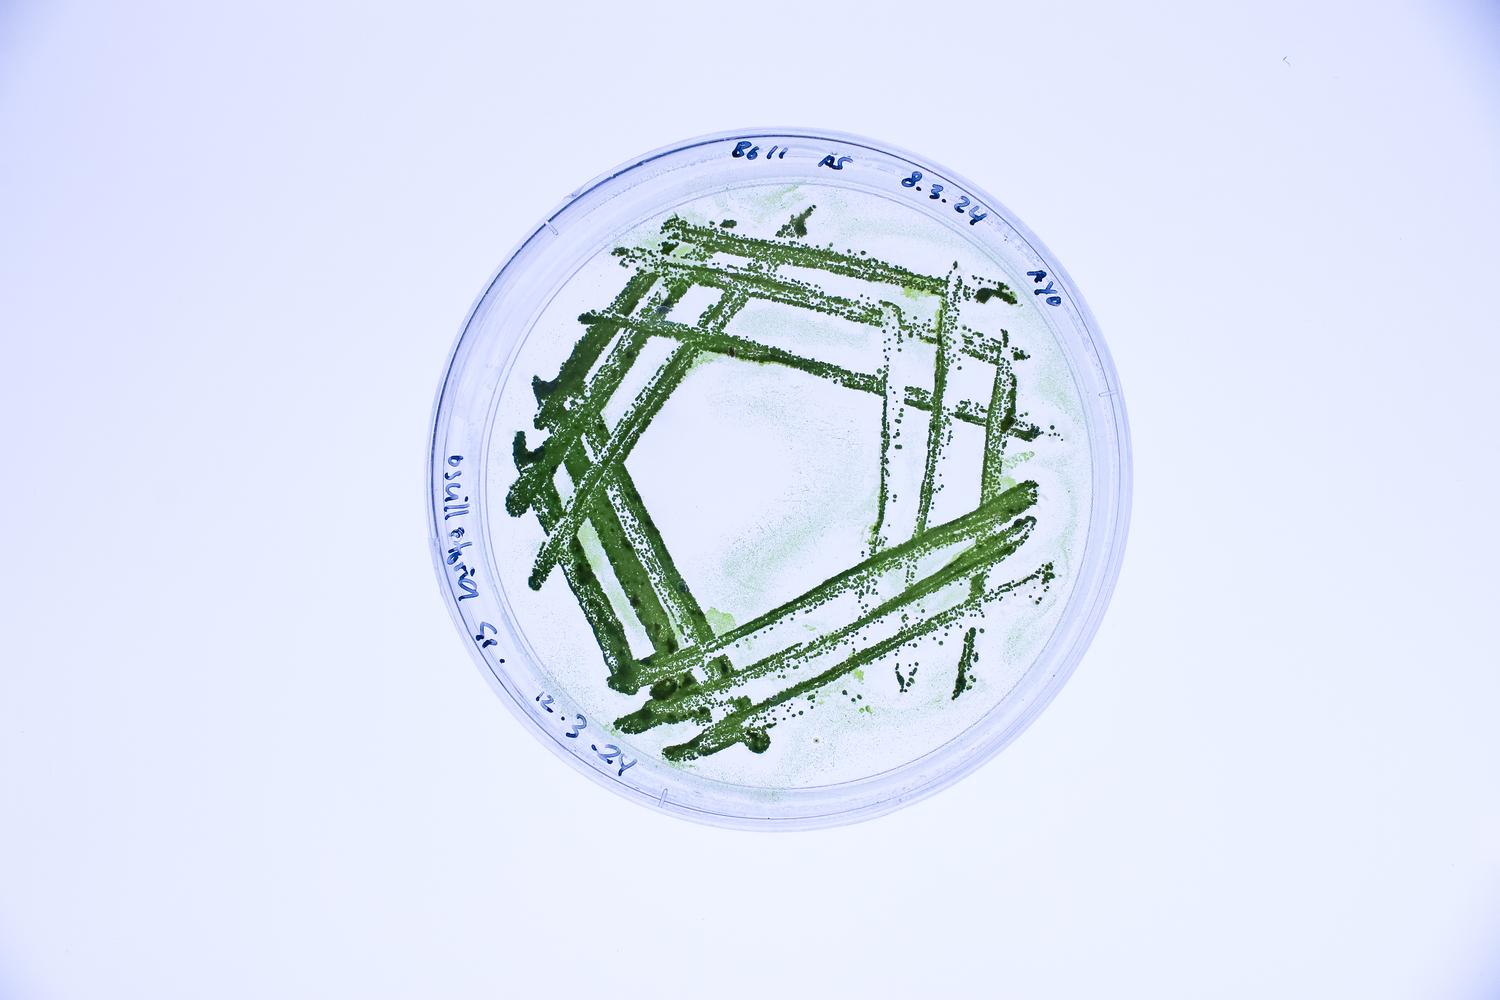

Together we can can transform early-stage projects into groundbreaking solutions.
We enable private companies, public organisations, and research teams to embed nature-inspired design principles, advanced biomaterials, and cellular engineering techniques into their innovation pipelines, fostering sustainable, cutting-edge solutions through project collaboration, specialist training and consultancy services.
Past & Ongoing Project Partners:
Lifefabs Institute also hosts MIT Media Lab Lab’s Synthetic Biology Course: HTGAA (How to Grow Almost Anything)
Learn About HTGAA